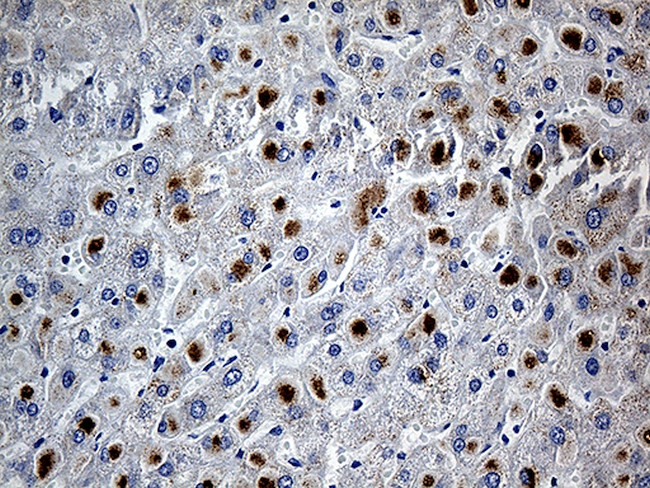
PLIN5 Antibody in Immunohistochemistry (Paraffin) (IHC (P))

Search
OriGene
PLIN5 Monoclonal Antibody (OTI3G4), TrueMAB™
{{$productOrderCtrl.translations['antibody.pdp.commerceCard.promotion.promotions']}}
{{$productOrderCtrl.translations['antibody.pdp.commerceCard.promotion.viewpromo']}}
{{$productOrderCtrl.translations['antibody.pdp.commerceCard.promotion.promocode']}}: {{promo.promoCode}} {{promo.promoTitle}} {{promo.promoDescription}}. {{$productOrderCtrl.translations['antibody.pdp.commerceCard.promotion.learnmore']}}
产品信息
TA811701
种属反应
宿主/亚型
分类
类型
克隆号
抗原
偶联物
形式
浓度
纯化类型
保存液
内含物
保存条件
运输条件
靶标信息
Lipid droplet-associated protein that maintains the balance between lipogenesis and lipolysis and also regulates fatty acid oxidation in oxidative tissues. Recruits mitochondria to the surface of lipid droplets and is involved in lipid droplet homeostasis by regulating both the storage of fatty acids in the form of triglycerides and the release of fatty acids for mitochondrial fatty acid oxidation. In lipid droplet triacylglycerol hydrolysis, plays a role as a scaffolding protein for three major key lipolytic players: ABHD5, PNPLA2 and LIPE. Reduces the triacylglycerol hydrolase activity of PNPLA2 by recruiting and sequestering PNPLA2 to lipid droplets. Phosphorylation by PKA enables lipolysis probably by promoting release of ABHD5 from the perilipin scaffold and by facilitating interaction of ABHD5 with PNPLA2. Also increases lipolysis through interaction with LIPE and upon PKA-mediated phosphorylation of LIPE.
仅用于科研。不用于诊断过程。未经明确授权不得转售。
篇参考文献 (0)
生物信息学
蛋白别名: Lipid storage droplet protein 5; Perilipin-5
基因别名: LSDA5; LSDP5; MLDP; OXPAT; PAT-1; PLIN5
UniProt ID: (Human) Q00G26
Entrez Gene ID: (Human) 440503